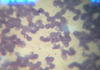
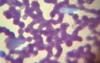
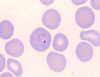
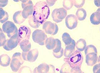
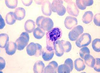
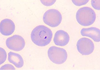
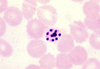
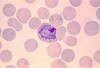
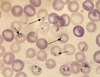
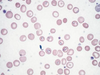
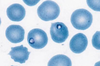
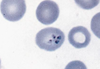
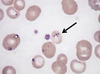
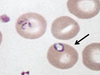
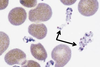

Apicomplexans and Ciliate Flashcards
(55 cards)

Balantidium coli (trophozoite)

Balantidium coli (trophozoite)

Balantidium coli (cyst)

Toxoplasma gondii (tachyzoites)

Toxoplasma gondii (tachyzoites)
Plasmodium falciparum (ring, trophozoite – note double chromatin dots)

Monocystis lumbrici (trophozoite)

Monocystis lumbrici (trophozoite)

Plasmodium falciparum (gametocyte)

Plasmodium vivax (ring, trophozoite)

Blastocystis hominis
Plasmodium vivax (ring, trophozoite – note Schuffner’s dots)
Plasmodium vivax (ring)
Plasmodium vivax (trophozoite)
Plasmodium vivax (schizont)

Plasmodium falciparum (ring – note double chromatin dots)

Plasmodium falciparum (ring – note multiple infections)

Plasmodium falciparum (gametocyte – note banana shape)

Plasmodium falciparum (early schizont)

Plasmodium ovale

Plasmodium spp. (exflagellation, microgametes)

Plasmodium spp. (sporozoites from salivary gland)

Plasmodium spp. (oocysts outside mosquito stomach)

Plasmodium spp. (cryptozoite in liver, will burst to release merozoites)